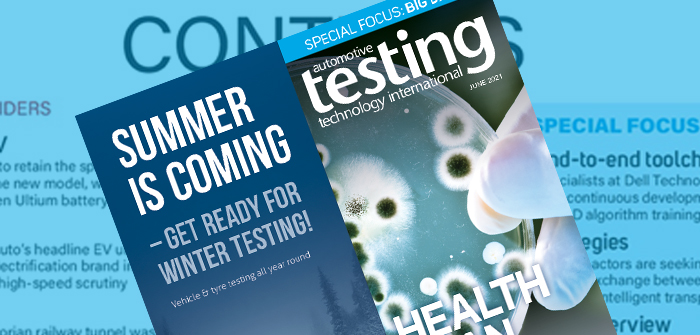

Download apps
Download the Automotive Testing Technology International App NOW to read the latest issue! The App is free and gives you access to a library of back issues.

Please contact us if you would like to receive a PDF copy of this publication or a specific feature listed below.
TECH INSIDER: ATTI gets the inside story on the development regime for the electric off-roader, which introduces GM’s next-gen Ultium battery tech.
HEALTH & WELL-BEING: An investigation into the latest wellness solutions being applied in cabins to enhance luxury and comfort.
SPECIAL FOCUS: Big Data – According to industry experts, new tools and methods are needed to handle the massive amounts of data generated during connected car testing.
SHOW PREVIEW: A complete preview to the open-air event in Hannover, which will feature ‘live’ demo vehicles with real-time 5G data streaming.
OEM INTERVIEW: Mazda’s Tomiko Takeuchi, program manager for the MX-30, recalls her highlights from a career that spans a wide range of roles in auto testing.
DIL SIMULATION: A tour of BMW’s new facility in Munich where engineers are learning to harness a suite of cutting-edge driving simulators.
Note to iPad and iPhone readers: to view this digital edition with the latest interactive features, please ensure you have upgraded your tablet or iPhone to at least the iOS 5 Operating System.
Note to Android tablet and Android phone readers: to view this digital edition with the latest interactive features, please ensure you have upgraded your tablet or Android phone to at least the Version 4.0 Operating System.